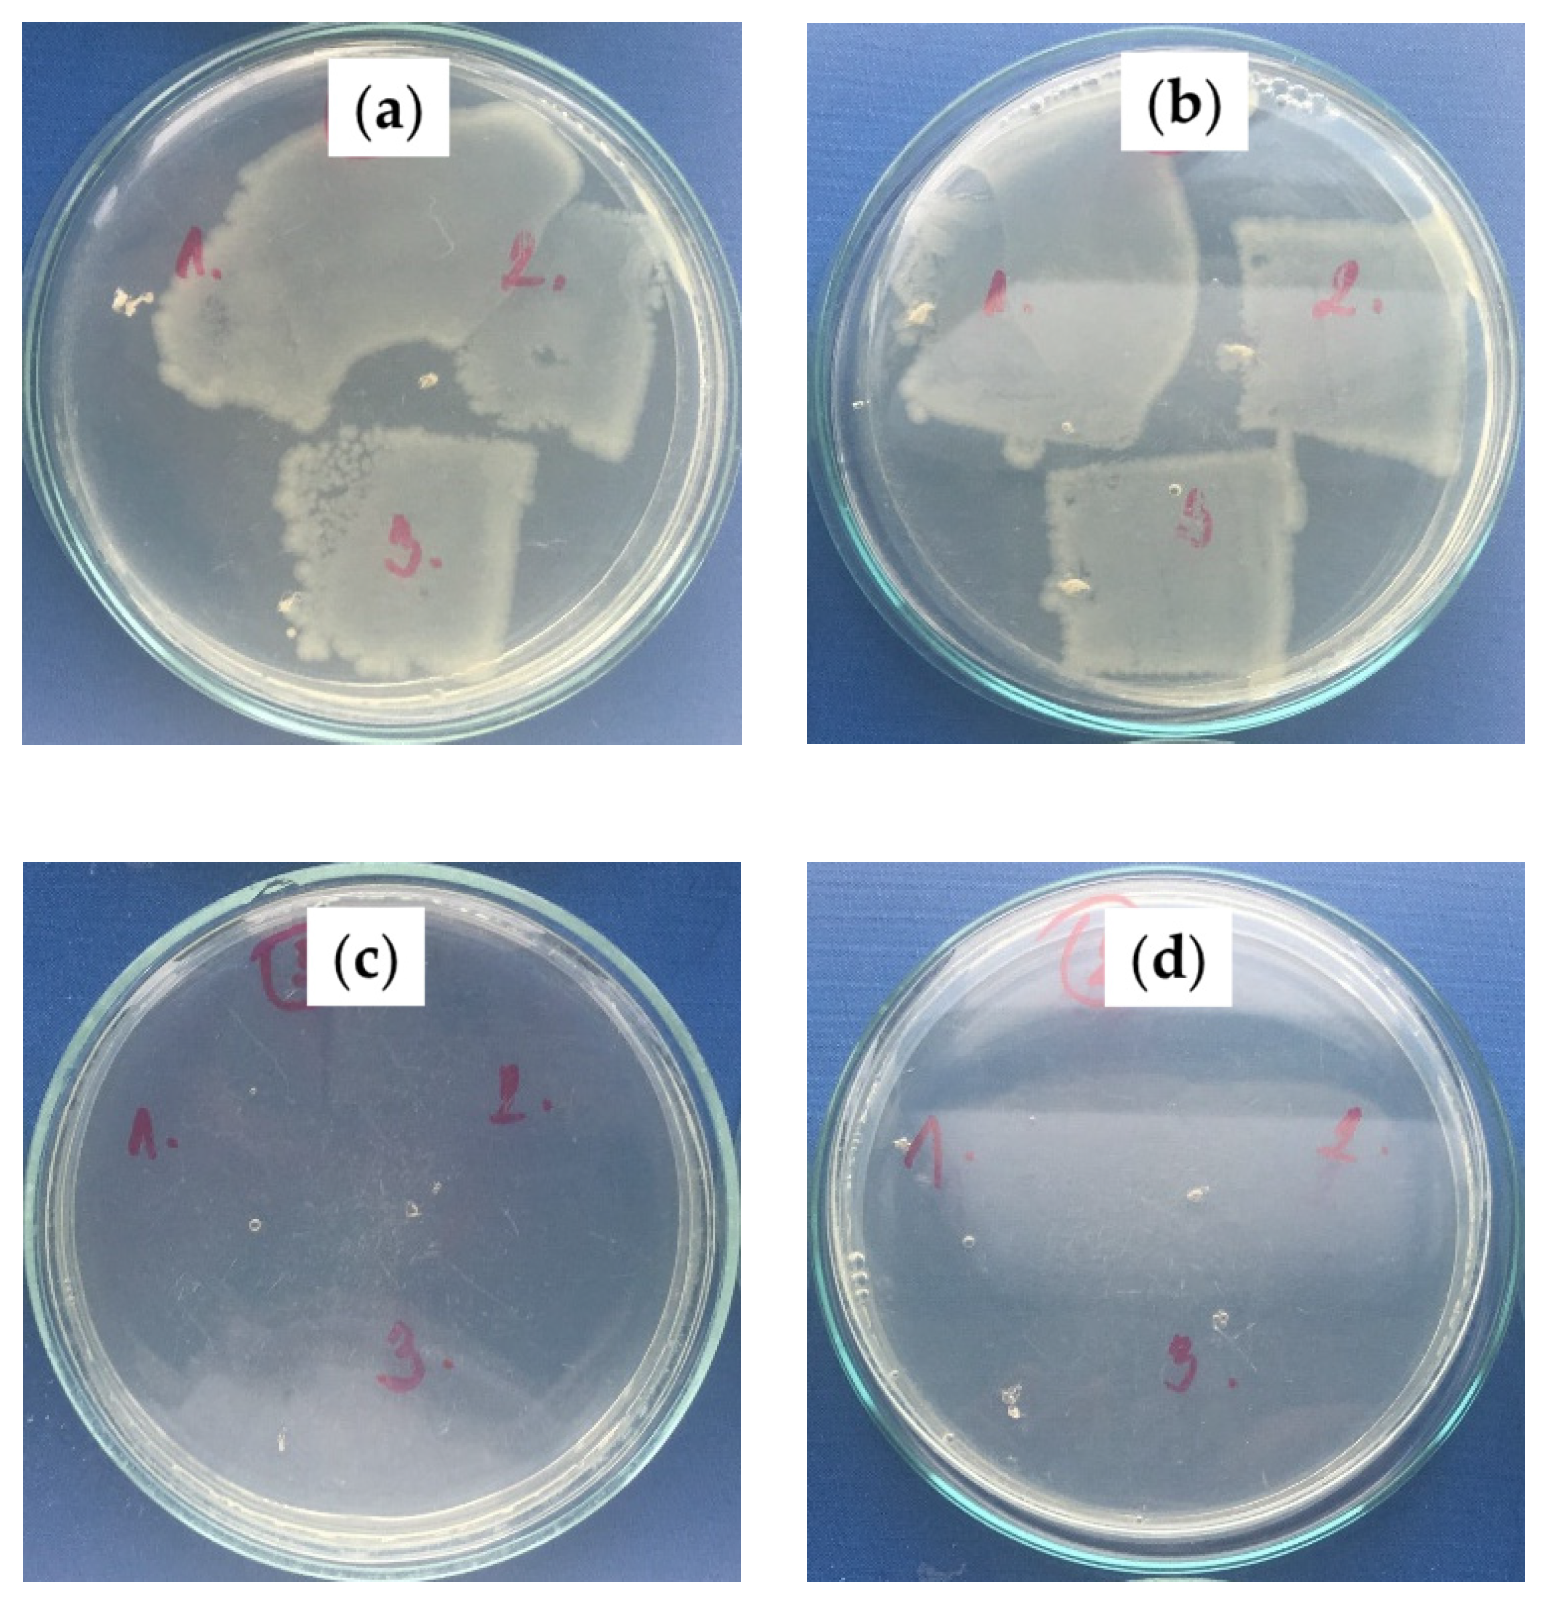
Ijms 23 03682 g009

Novel Slippery Liquid-Infused Porous Surfaces (SLIPS) Based on Electrospun Polydimethylsiloxane/Polystyrene Fibrous Structures Infused with Natural Blackseed Oil
Abstract
:1. Introduction
2. Results and Discussion
2.1. Fiber Mat Characterization
2.1.1. Surface Morphology/Topography Analysis
2.1.2. Characterization of Mechanical Properties Characterization
2.1.3. Chemical Composition Analyses
2.1.4. Adhesion Investigation
2.2. Characterization of SLIPs
2.2.1. Surface Morphology/Topography Analysis
2.2.2. Slippery Behavior Investigation
2.2.3. Antibacterial Activity Investigation
3. Materials and Methods
3.1. Material
3.2. Procedure
3.2.1. Plasma Treatment
3.2.2. Electrospinning Procedure
3.2.3. Oil Infusion
3.2.4. Surface Energy and Slippery Effect Investigation
3.2.5. Surface Morphology/Topography Analysis
3.2.6. Investigation of Mechanical Properties
3.2.7. Adhesion Investigation
3.2.8. Chemical Composition Analyses
3.2.9. Antibacterial Tests
4. Conclusions
Author Contributions
Funding
Institutional Review Board Statement
Informed Consent Statement
Data Availability Statement
Acknowledgments
Conflicts of Interest
References
- Lejars, M.; Margaillan, A.; Bressy, C. Fouling release coatings: A nontoxic alternative to biocidal antifouling coatings. Chem. Rev. 2012, 112, 4347–4390. [Google Scholar] [CrossRef] [PubMed]
- Sanchez-Cano, C.; Carril, M. Recent developments in the design of non-biofouling coatings for nanoparticles and surfaces. Int. J. Mol. Sci. 2020, 21, 1007. [Google Scholar] [CrossRef] [PubMed] [Green Version]
- Li, Q.; Guo, Z. Lubricant-infused slippery surfaces: Facile fabrication, unique liquid repellence and antireflective properties. J. Colloid Interface Sci. 2019, 536, 507–515. [Google Scholar] [CrossRef]
- Zhou, T.; Yang, J.; Zhu, D.; Zheng, J.; Handschuh-Wang, S.; Zhou, X.; Zhang, J.; Liu, Y.; Liu, Z.; He, C.; et al. Hydrophilic Sponges for Leaf-Inspired Continuous Pumping of Liquids. Adv. Sci. 2017, 4, 1700028. [Google Scholar] [CrossRef]
- Cui, Y.; Li, D.; Bai, H. Bioinspired Smart Materials for Directional Liquid Transport. Ind. Eng. Chem. Res. 2017, 56, 4887–4897. [Google Scholar] [CrossRef]
- Chen, X.; Ren, K.; Wang, J.; Lei, W.; Ji, J. Infusing Lubricant onto Erasable Microstructured Surfaces toward Guided Sliding of Liquid Droplets. ACS Appl. Mater. Interfaces 2017, 9, 1959–1967. [Google Scholar] [CrossRef]
- Cao, M.; Jin, X.; Peng, Y.; Yu, C.; Li, K.; Liu, K.; Jiang, L. Unidirectional Wetting Properties on Multi-Bioinspired Magnetocontrollable Slippery Microcilia. Adv. Mater. 2017, 29, 1606869. [Google Scholar] [CrossRef]
- Lv, J.; Liu, Y.; Wei, J.; Chen, E.; Qin, L.; Yu, Y. Photocontrol of fluid slugs in liquid crystal polymer microactuators. Nature 2016, 537, 179. [Google Scholar] [CrossRef]
- Dinh, N.X.; Chi, D.T.; Lan, N.T.; Lan, H.; Van Tuan, H.; Van Quy, N.; Phan, V.N.; Huy, T.Q.; Le, A.-T. Water-dispersible silver nanoparticles-decorated carbon nanomaterials: Synthesis and enhanced antibacterial activity. Appl. Phys. A 2015, 119, 85–95. [Google Scholar] [CrossRef]
- Yuan, W.; Jiang, G.; Che, J.; Qi, X.; Xu, R.; Chang, M.W.; Chen, Y.; Lim, S.Y.; Dai, J.; Chan-Park, M.B. Deposition of Silver Nanoparticles on Multiwalled Carbon Nanotubes Grafted with Hyperbranched Poly(amidoamine) and Their Antimicrobial Effects. J. Phys. Chem. C 2008, 112, 18754–18759. [Google Scholar] [CrossRef]
- Liao, C.; Li, Y.; Tjong, S.C. Graphene nanomaterials: Synthesis, biocompatibility, and cytotoxicity. Int. J. Mol. Sci. 2018, 19, 3564. [Google Scholar] [CrossRef] [PubMed] [Green Version]
- Armendáriz-Ontiveros, M.M.; García García, A.; de los Santos Villalobos, S.; Fimbres Weihs, G.A. Biofouling performance of RO membranes coated with Iron NPs on graphene oxide. Desalination 2019, 451, 45–58. [Google Scholar] [CrossRef]
- Park, K.C.; Kim, P.; Grinthal, A.; He, N.; Fox, D.; Weaver, J.C.; Aizenberg, J. Condensation on slippery asymmetric bumps. Nature 2016, 531, 78–82. [Google Scholar] [CrossRef] [PubMed] [Green Version]
- Wong, T.S.; Kang, S.H.; Tang, S.K.Y.; Smythe, E.J.; Hatton, B.D.; Grinthal, A.; Aizenberg, J. Bioinspired self-repairing slippery surfaces with pressure-stable omniphobicity. Nature 2011, 477, 443–447. [Google Scholar] [CrossRef] [PubMed]
- Zhang, X.; Zhi, D.; Sun, L.; Zhao, Y.; Tiwari, M.K.; Carmalt, C.J.; Parkin, I.P.; Lu, Y. Super-durable, non-fluorinated superhydrophobic free-standing items. J. Mater. Chem. A 2018, 6, 357–362. [Google Scholar] [CrossRef] [Green Version]
- Jia, S.; Chen, H.; Luo, S.; Qing, Y.; Deng, S.; Yan, N.; Wu, Y. One-step approach to prepare superhydrophobic wood with enhanced mechanical and chemical durability: Driving of alkali. Appl. Surf. Sci. 2018, 455, 115–122. [Google Scholar] [CrossRef]
- Chen, H.; Zhang, P.; Zhang, L.; Liu, H.; Jiang, Y.; Zhang, D.; Han, Z.; Jiang, L. Continuous directional water transport on the peristome surface of Nepenthes alata. Nature 2016, 532, 85–89. [Google Scholar] [CrossRef]
- Niu, H.; Wang, H.; Zhou, H.; Lin, T. Ultrafine PDMS fibers: Preparation from in situ curing-electrospinning and mechanical characterization. RSC Adv. 2014, 4, 11782–11787. [Google Scholar] [CrossRef]
- Cortese, B.; D’Amone, S.; Manca, M.; Viola, I.; Cingolani, R.; Gigli, G. Superhydrophobicity Due to the Hierarchical Scale Roughness of PDMS Surfaces. Langmuir 2008, 24, 2712–2718. [Google Scholar] [CrossRef]
- Nakajima, A.; Fujishima, A.; Hashimoto, K.; Watanabe, T. Preparation of transparent superhydrophobic boehmite and silica films by sublimation of aluminum acetylacetonate. Adv. Mater. 1999, 11, 1365–1368. [Google Scholar] [CrossRef]
- Li, L.; Xiao, Z.; Tan, S.; Pu, L.; Zhang, Z. Composite PDMS membrane with high flux for the separation of organics from water by pervaporation. J. Memb. Sci. 2004, 243, 177–187. [Google Scholar] [CrossRef]
- Fujii, T. PDMS-based microfluidic devices for biomedical applications. Microelectron. Eng. 2002, 61–62, 907–914. [Google Scholar] [CrossRef]
- Jin, M.; Feng, X.; Xi, J.; Zhai, J.; Cho, K.; Feng, L.; Jiang, L. Super-Hydrophobic PDMS Surface with Ultra-Low Adhesive Force. Macromol. Rapid Commun. 2005, 26, 1805–1809. [Google Scholar] [CrossRef]
- Brady, R.F.; Singer, I.L. Mechanical factors favoring release from fouling release coatings. Biofouling 2000, 15, 73–81. [Google Scholar] [CrossRef]
- Kuliasha, C.A.; Finlay, J.A.; Franco, S.C.; Clare, A.S.; Stafslien, S.J.; Brennan, A.B. Marine anti-biofouling efficacy of amphiphilic poly(coacrylate) grafted PDMSe: Effect of graft molecular weight. Biofouling 2017, 33, 252–267. [Google Scholar] [CrossRef]
- Tribou, M.; Swain, G. The use of proactive in-water grooming to improve the performance of ship hull antifouling coatings. Biofouling 2010, 26, 47–56. [Google Scholar] [CrossRef]
- Shivapooja, P.; Yu, Q.; Orihuela, B.; Mays, R.; Rittschof, D.; Genzer, J.; López, G.P. Modification of Silicone Elastomer Surfaces with Zwitterionic Polymers: Short-Term Fouling Resistance and Triggered Biofouling Release. ACS Appl. Mater. Interfaces 2015, 7, 25586–25591. [Google Scholar] [CrossRef]
- Wang, J.; He, C. Photopolymerized biomimetic self-adhesive Polydimethylsiloxane-based amphiphilic cross-linked coating for anti-biofouling. Appl. Surf. Sci. 2019, 463, 1097–1106. [Google Scholar] [CrossRef]
- Demir, M.M.; Yilgor, I.; Yilgor, E.; Erman, B. Electrospinning of polyurethane fibers. Polymer 2002, 43, 3303–3309. [Google Scholar] [CrossRef]
- Greiner, A.; Wendorff, J.H. Electrospinning: A fascinating method for the preparation of ultrathin fibers. Angew. Chem. Int. Ed. Engl. 2007, 46, 5670–5703. [Google Scholar] [CrossRef]
- Li, D.; Xia, Y. Direct Fabrication of Composite and Ceramic Hollow Nanofibers by Electrospinning. Nano Lett. 2004, 4, 933–938. [Google Scholar] [CrossRef]
- Reneker, D.H.; Chun, I. Nanometre diameter fibres of polymer, produced by electrospinning. Nanotechnology 1996, 7, 216–223. [Google Scholar] [CrossRef] [Green Version]
- Uyar, T.; Besenbacher, F. Electrospinning of uniform polystyrene fibers: The effect of solvent conductivity. Polymer 2008, 49, 5336–5343. [Google Scholar] [CrossRef]
- Nitanan, T.; Akkaramongkolporn, P.; Ngawhirunpat, T.; Rojanarata, T.; Panomsuk, S.; Opanasopit, P. Fabrication and evaluation of cationic exchange nanofibers for controlled drug delivery systems. Int. J. Pharm. 2013, 450, 345–353. [Google Scholar] [CrossRef] [PubMed]
- Emo, B.; Eberlin, C.T.; Hixon, K.R.; Growney Kalaf, E.A.; Laktas, J.M.; Sell, S.A. A study on the potential of doped electrospun polystyrene fibers in arsenic filtration. J. Environ. Chem. Eng. 2017, 5, 232–239. [Google Scholar] [CrossRef]
- Jia, H.; Zhu, G.; Vugrinovich, B.; Kataphinan, W.; Reneker, D.H.; Wang, P. Enzyme-carrying polymeric nanofibers prepared via electrospinning for use as unique biocatalysts. Biotechnol. Prog. 2002, 18, 1027–1032. [Google Scholar] [CrossRef]
- Baker, S.C.; Atkin, N.; Gunning, P.A.; Granville, N.; Wilson, K.; Wilson, D.; Southgate, J. Characterisation of electrospun polystyrene scaffolds for three-dimensional in vitro biological studies. Biomaterials 2006, 27, 3136–3146. [Google Scholar] [CrossRef]
- Bassi, A.K.; Gough, J.E.; Zakikhani, M.; Downes, S. The chemical and physical properties of poly(ε-caprolactone) scaffolds functionalised with poly(vinyl phosphonic acid-co-acrylic acid). J. Tissue Eng. 2011, 2, 1–9. [Google Scholar] [CrossRef]
- Larrondo, L.; Manley, R.S.J. Electrostatic fiber spinning from polymer melts. I. Experimental observations on fiber formation and properties. J. Polym. Sci. Polym. Phys. Ed. 1981, 19, 909–920. [Google Scholar] [CrossRef]
- Liu, H.; Gough, C.R.; Deng, Q.; Gu, Z.; Wang, F.; Hu, X. Recent advances in electrospun sustainable composites for biomedical, environmental, energy, and packaging applications. Int. J. Mol. Sci. 2020, 21, 4019. [Google Scholar] [CrossRef]
- Huang, Z.M.; Zhang, Y.Z.; Kotaki, M.; Ramakrishna, S. A review on polymer nanofibers by electrospinning and their applications in nanocomposites. Compos. Sci. Technol. 2003, 63, 2223–2253. [Google Scholar] [CrossRef]
- Deitzel, J.M.; Kleinmeyer, J.; Harris, D.; Beck Tan, N.C. The effect of processing variables on the morphology of electrospun nanofibers and textiles. Polymer 2001, 42, 261–272. [Google Scholar] [CrossRef]
- Haider, S.; Al-Zeghayer, Y.; Ahmed Ali, F.A.; Haider, A.; Mahmood, A.; Al-Masry, W.A.; Imran, M.; Aijaz, M.O. Highly aligned narrow diameter chitosan electrospun nanofibers. J. Polym. Res. 2013, 20, 105. [Google Scholar] [CrossRef]
- Matabola, K.P.; Moutloali, R.M. The influence of electrospinning parameters on the morphology and diameter of poly(vinyledene fluoride) nanofibers- Effect of sodium chloride. J. Mater. Sci. 2013, 48, 5475–5482. [Google Scholar] [CrossRef]
- Mohammed, S.J.; Amin, H.H.H.; Aziz, S.B.; Sha, A.M.; Hassan, S.; Abdul Aziz, J.M.; Rahman, H.S. Structural Characterization, Antimicrobial Activity, and in Vitro Cytotoxicity Effect of Black Seed Oil. Evid. -Based Complement. Altern. Med. 2019, 2019. [Google Scholar] [CrossRef] [Green Version]
- Dinagaran, S.; Sridhar, S.; Eganathan, P. Chemical composition and antioxidant activities of black seed oil (Nigella sativa L.). Int. J. Pharm. Sci. Res. 2016, 7, 4473. [Google Scholar] [CrossRef]
- Nair, M.K.M.; Vasudevan, P.; Venkitanarayanan, K. Antibacterial effect of black seed oil on Listeria monocytogenes. Food Control 2005, 16, 395–398. [Google Scholar] [CrossRef]
- Moghadas, H.; Saidi, M.S.; Kashaninejad, N.; Kiyoumarsioskouei, A.; Nguyen, N.T. Fabrication and characterization of low-cost, bead-free, durable and hydrophobic electrospun membrane for 3D cell culture. Biomed. Microdevices 2017, 19, 74. [Google Scholar] [CrossRef] [Green Version]
- Izdihar, K.; Razak, H.R.A.; Supion, N.; Karim, M.K.A.; Osman, N.H.; Norkhairunnisa, M. Structural, mechanical, and dielectric properties of polydimethylsiloxane and silicone elastomer for the fabrication of clinical-grade kidney phantom. Appl. Sci. 2021, 11, 1172. [Google Scholar] [CrossRef]
- Al-Kadhemy, M.F.H.; Rasheed, Z.S.; Salim, S.R. Fourier transform infrared spectroscopy for irradiation coumarin doped polystyrene polymer films by alpha ray. J. Radiat. Res. Appl. Sci. 2016, 9, 321–331. [Google Scholar] [CrossRef] [Green Version]
- Johnson, L.M.; Gao, L.; Shields, C.W.; Smith, M.; Efimenko, K.; Cushing, K.; Genzer, J.; López, G.P. Elastomeric microparticles for acoustic mediated bioseparations. J. Nanobiotechnol. 2013, 11, 22. [Google Scholar] [CrossRef] [PubMed] [Green Version]
- Abusrafa, A.E.; Habib, S.; Krupa, I.; Ouederni, M.; Popelka, A. Modification of polyethylene by RF plasma in different/mixture gases. Coatings 2019, 9, 145. [Google Scholar] [CrossRef] [Green Version]
- Abusrafa, A.E.; Habib, S.; Popelka, A. Surface functionalization of a polyurethane surface via radio-frequency cold plasma treatment using different gases. Coatings 2020, 10, 1067. [Google Scholar] [CrossRef]
- Oliver, W.C.; Pharr, G.M. An improved technique for determining hardness and elastic modulus using load and displacement sensing indentation experiments. J. Mater. Res. 1992, 7, 1564–1583. [Google Scholar] [CrossRef]

| Polymer Mixture | Solvent | |
|---|---|---|
| PS | PDMS | THF |
| (g) | (g) | (mL) |
| 0.5 | 1 | 10 |
| 1 | 1 | 10 |
| 1.5 | 1 | 10 |
| 1 | 1 | 8 |
| 1 | 1 | 6 |
| Polymer | WCA (°) | WCA Image |
|---|---|---|
| 0.5 g:1 g PS: PDMS in 10 mL THF | 127.4 (±2.4) | ![]() |
| 1 g:1 g PS: PDMS in 10 mL THF | 149.4 (±3.2) | ![]() |
| 1 g:1 g PS: PDMS in 8 mL THF | 124.0 (±3.6) | ![]() |
| 1.5 g:1 g PS: PDMS in 10 mL THF | 141.3 (±3.8) | ![]() |
| Sample | Ec (MPa) | SD | Hardness (MPa) | SD |
|---|---|---|---|---|
| PS | 3.4 | 0.7 | 0.4 | 0.2 |
| PS/PDMS | 7.2 | 1.2 | 1.1 | 0.3 |
| Sample | Increase in Bacterial Colonies * | |
|---|---|---|
| S. aureus CCM 4516 | E. coli CCM 4517 | |
| PS/PDMS-PE (no oil) | 4–5, 4, 4 | 5, 5, 5 |
| PS/PDMS-PU (no oil) | 4–5, 4–5, 4–5 | 5, 4–5, 5 |
| PS/PDMS/BSO-PE | 0, 0, 0 | 0, 0, 0 |
| PS/PDMS/BSO-PU | 0, 0, 0 | 0, 0–1, 0–1 |
Publisher’s Note: MDPI stays neutral with regard to jurisdictional claims in published maps and institutional affiliations. |
© 2022 by the authors. Licensee MDPI, Basel, Switzerland. This article is an open access article distributed under the terms and conditions of the Creative Commons Attribution (CC BY) license (https://creativecommons.org/licenses/by/4.0/).
Share and Cite
Abdulkareem, A.; Abusrafa, A.E.; Zavahir, S.; Habib, S.; Sobolčiak, P.; Lehocky, M.; Pištěková, H.; Humpolíček, P.; Popelka, A. Novel Slippery Liquid-Infused Porous Surfaces (SLIPS) Based on Electrospun Polydimethylsiloxane/Polystyrene Fibrous Structures Infused with Natural Blackseed Oil. Int. J. Mol. Sci. 2022, 23, 3682. https://doi.org/10.3390/ijms23073682
Abdulkareem A, Abusrafa AE, Zavahir S, Habib S, Sobolčiak P, Lehocky M, Pištěková H, Humpolíček P, Popelka A. Novel Slippery Liquid-Infused Porous Surfaces (SLIPS) Based on Electrospun Polydimethylsiloxane/Polystyrene Fibrous Structures Infused with Natural Blackseed Oil. International Journal of Molecular Sciences. 2022; 23(7):3682. https://doi.org/10.3390/ijms23073682
Chicago/Turabian StyleAbdulkareem, Asma, Aya E. Abusrafa, Sifani Zavahir, Salma Habib, Patrik Sobolčiak, Marian Lehocky, Hana Pištěková, Petr Humpolíček, and Anton Popelka. 2022. "Novel Slippery Liquid-Infused Porous Surfaces (SLIPS) Based on Electrospun Polydimethylsiloxane/Polystyrene Fibrous Structures Infused with Natural Blackseed Oil" International Journal of Molecular Sciences 23, no. 7: 3682. https://doi.org/10.3390/ijms23073682
APA StyleAbdulkareem, A., Abusrafa, A. E., Zavahir, S., Habib, S., Sobolčiak, P., Lehocky, M., Pištěková, H., Humpolíček, P., & Popelka, A. (2022). Novel Slippery Liquid-Infused Porous Surfaces (SLIPS) Based on Electrospun Polydimethylsiloxane/Polystyrene Fibrous Structures Infused with Natural Blackseed Oil. International Journal of Molecular Sciences, 23(7), 3682. https://doi.org/10.3390/ijms23073682





